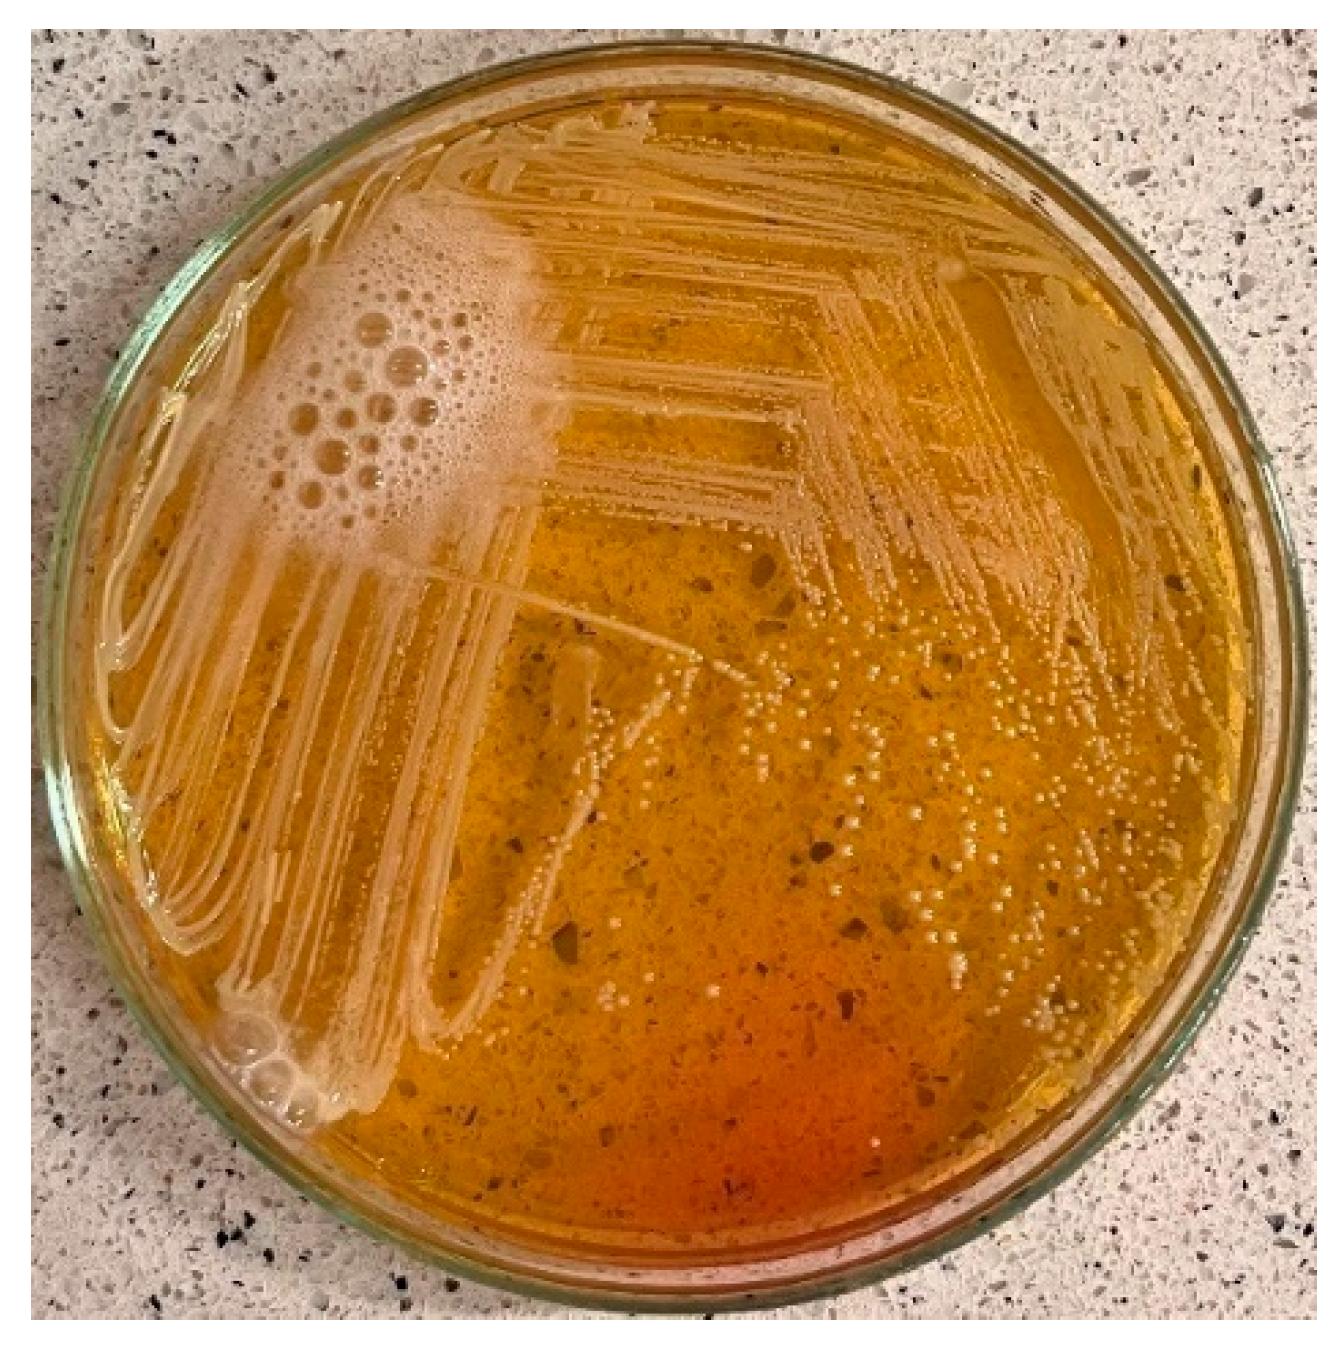
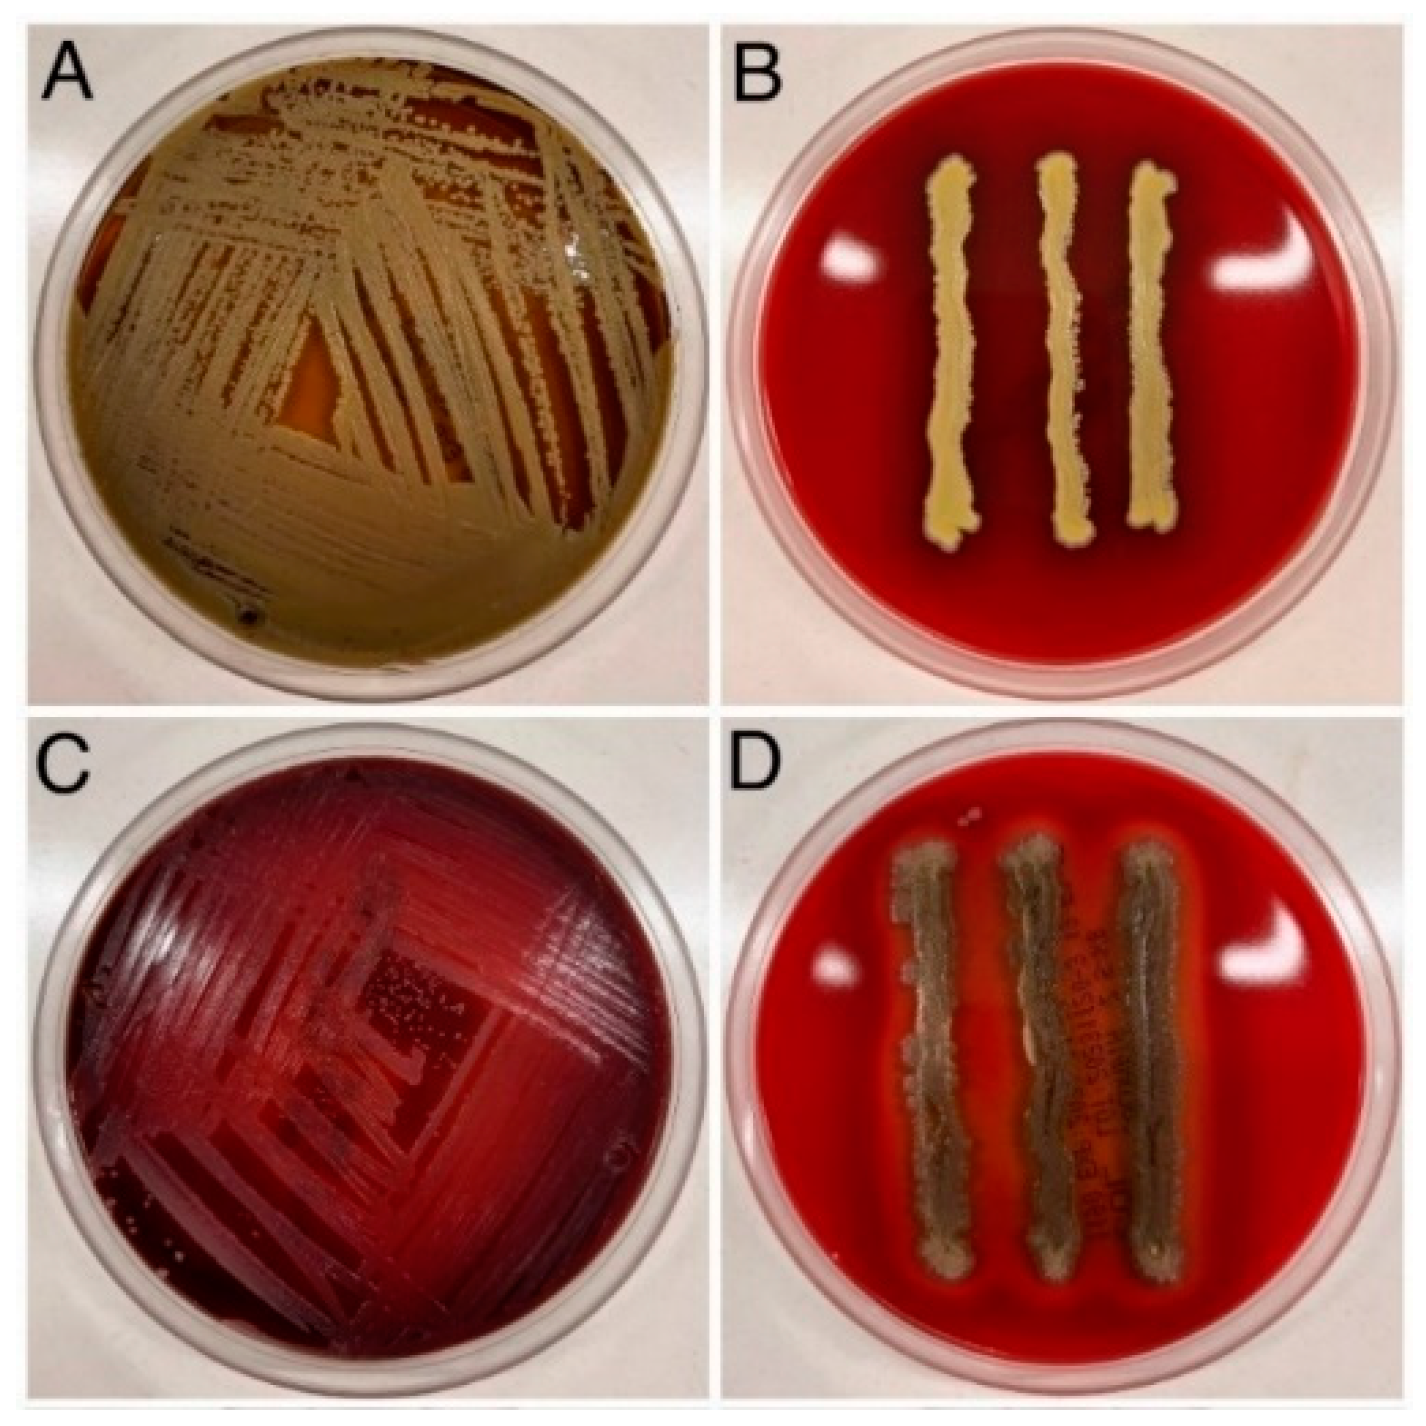

Occurrence and Phenotypic Characteristics of Methicillin-Resistant Staphylococcus aureus (MRSA) in Emergency Medical Service Ambulances as a Potential Threat to Medical Staff and Patients
Abstract
1. Introduction
2. Materials and Methods
2.1. Bacterial Strains
2.2. Clumping Factor (CF) Test
2.3. Catalase Test
2.4. Gram Staining
2.5. Test of Strain Resistance to Selected Antibiotics
3. Results
3.1. Evaluation of Growth on Chapman Substrate
Evaluation of the CF Tests, Catalase Tests, and Gram-Stained Slides
3.2. Evaluation of Haemolytic Properties
3.3. Antibiotic Resistance Evaluation of Tested Strains
4. Discussion
- Performing a nasal swab screening test on a person suspected of being infected with or carrying S. aureus. According to the Polish Regulation of the Minister of Health of 7 March 2024, Section 30, paramedics have the ability to collect upper respiratory tract specimens from a patient (this gives medical personnel the ability to identify a person requiring isolation).
- Hand hygiene. Evaluation of the effectiveness of hand washing procedures and the use of antiseptics by paramedics according to the 2009 WHO guidelines. The procedure recommends hand hygiene using an alcohol-based preparation in eight steps, for 20–30 s, and emphasises the use of gloves, which should be used for one patient. This point also includes the supply of hand sanitising agents to medical personnel in the patient area not more than 1–1.5 m away from the patient.
- Isolation of the infected patient. When an infection is suspected or confirmed by screening test, paramedics should be trained in the proper use of precautions such as contact isolation to prevent the spread of bacteria. Additionally, it may be helpful to introduce disposable patient bedding/blankets into ambulances, which can be disposed of or sterilised after use. This can help reduce the spread of microorganisms around the ambulance.
- Assessment of the availability and use of appropriate disinfectants and cleaning procedures for medical equipment and surfaces to prevent bacterial spread.
- Evaluation of the effectiveness of procedures to monitor and report S. aureus infection cases in a medical facility and the effectiveness of actions taken in response to these reports. Identification of an infected patient who was transported to the hospital by ambulance should result in notifying the emergency medical service dispatcher about such an event in order to perform additional decontamination of the ambulance and the team.
- Analysis of data on changes in the incidence of S aureus infections over time allows for the effectiveness of prevention and control strategies to be assessed and areas for improvement identified.
- Public education. Increasing patient awareness about the routes of transmission and disease caused by Staphylococcus aureus can help reduce the risk of infection by promoting proper hand hygiene, using appropriate personal protective equipment, and encouraging the reporting of any signs of infection to medical personnel [34].
Limitations of the Study
5. Conclusions
Author Contributions
Funding
Institutional Review Board Statement
Informed Consent Statement
Data Availability Statement
Conflicts of Interest
References
- Algammal, A.M.; Hetta, H.F.; Elkelish, A.; Alkhalifah, D.H.H.; Hozzein, W.N.; Batiha, G.E.; El Nahhas, N.; Mabrok, M.A. Methicillin-Resistant Staphylococcus aureus (MRSA): One Health Perspective Approach to the Bacterium Epidemiology, Virulence Factors, Antibiotic-Resistance, and Zoonotic Impact. Infect. Drug Resist. 2020, 13, 3255–3265. [Google Scholar] [CrossRef]
- Antimicrobial Resistance Surveillance in Europe 2023–2021 Data. Stockholm: European Centre for Disease Prevention and Control and World Health Organization. 2023. Available online: https://www.ecdc.europa.eu/en/publications-data/antimicrobial-resistance-surveillance-europe-2023-2021-data (accessed on 10 August 2024).
- Hasanpour, A.H.; Sepidarkish, M.; Mollalo, A.; Ardekani, A.; Almukhtar, M.; Mechaal, A.; Hosseini, S.R.; Bayani, M.; Javanian, M.; Rostami, A. The global prevalence of methicillin-resistant Staphylococcus aureus colonization in residents of elderly care centers: A systematic review and meta-analysis. Antimicrob. Resist. Infect. Control 2023, 12, 4. [Google Scholar] [CrossRef]
- Batabyal, B.; Kundu, G.; Biswas, S. Methicillin-Resistant Staphylococcus Aureus: A Brief Review. Int. Res. J. Biol. Sci. 2012, 1, 65–71. [Google Scholar]
- Meyer, F.; Girardot, R.; Piémont, Y.; Prévost, G.; Colin, D.A. Analysis of the specificity of Panton-Valentine leukocidin and gamma-hemolysin F component binding. Infect. Immun. 2009, 77, 266–273. [Google Scholar] [CrossRef]
- Lee, A.S.; de Lencastre, H.; Garau, J.; Kluytmans, J.; Malhotra-Kumar, S.; Peschel, A.; Harbarth, S. Methicillin-resistant Staphylococcus aureus. Nat. Rev. Dis. Primers 2018, 4, 18033. [Google Scholar] [CrossRef] [PubMed]
- Cheung, G.Y.; Duong, A.C.; Otto, M. Direct and synergistic hemolysis caused by Staphylococcus phenol-soluble modulins: Implications for diagnosis and pathogenesis. Microbes Infect. 2012, 14, 380–386. [Google Scholar] [CrossRef] [PubMed]
- Bhakdi, S.; Tranum-Jensen, J. Alpha-toxin of Staphylococcus aureus. Microbiol. Rev. 1991, 55, 733–751. [Google Scholar] [CrossRef] [PubMed]
- Otto, M. MRSA virulence and spread. Cell. Microbiol. 2012, 14, 1513–1521. [Google Scholar] [CrossRef]
- Kourtis, A.P.; Hatfield, K.; Baggs, J.; Mu, Y.; See, I.; Epson, E.; Nadle, J.; Kainer, M.A.; Dumyati, G.; Petit, S.; et al. Vital Signs: Epidemiology and Recent Trends in Methicillin-Resistant and in Methicillin-Susceptible Staphylococcus aureus Bloodstream Infections—United States. MMWR Morb. Mortal. Wkly. Rep. 2019, 68, 214–219. [Google Scholar] [CrossRef] [PubMed]
- Vanhommerig, E.; Moons, P.; Pirici, D.; Lammens, C.; Hernalsteens, J.P.; De Greve, H.; Kumar-Singh, S.; Goossens, H.; Malhotra-Kumar, S. Comparison of biofilm formation between major clonal lineages of methicillin-resistant Staphylococcus aureus. PLoS ONE 2014, 9, e104561. [Google Scholar] [CrossRef]
- Beenken, K.E.; Blevins, J.S.; Smeltzer, M.S. Mutation of sarA in Staphylococcus aureus Limits Biofilm Formation. Infect. Immun. 2003, 71, 4206–4211. [Google Scholar] [CrossRef] [PubMed]
- Uruén, C.; Chopo-Escuin, G.; Tommassen, J.; Mainar-Jaime, R.C.; Arenas, J. Biofilms as Promoters of Bacterial Antibiotic Resistance and Tolerance. Antibiotics 2020, 10, 3. [Google Scholar] [CrossRef] [PubMed]
- Høiby, N.; Ciofu, O.; Johansen, H.K.; Song, Z.-J.; Moser, C.; Jensen, P.Ø.; Molin, S.; Givskov, M.; Tolker-Nielsen, T.; Bjarnsholt, T. The clinical impact of bacterial biofilms. Int. J. Oral Sci. 2011, 3, 55–65. [Google Scholar] [CrossRef]
- Leszczyński, P.; Kalinowska, J.; Mitura, K.; Sholokhova, D. Injuries to users of single-track vehicles. Int. J. Environ. Res. Public Health 2022, 19, 12112. [Google Scholar] [CrossRef]
- Leszczyński, P.; Mioduski, M.; Gałązkowski, R. The NACA score as a predictor of ventricular cardiac arrhythmias—A retrospective six-year study. Am. J. Emerg. Med. 2020, 38, 2249–2253. [Google Scholar] [CrossRef] [PubMed]
- Leszczyński, P.K.; Sobolewska, P.; Muraczyńska, B.; Gryz, P.; Kwapisz, A. Impact of COVID-19 Pandemic on Quality of Health Services Provided by Emergency Medical Services and Emergency Departments in the Opinion of Patients: Pilot Study. Int. J. Environ. Res. Public Health 2022, 19, 1232. [Google Scholar] [CrossRef] [PubMed]
- Świeżewski, S.P.; Wejnarski, A.; Leszczyński, P.K.; Wojak, A.; Fronczak, A.; Darocha, T.; Gałązkowski, R.; Opolski, G.; Rzońca, P. Characteristics of urban vs rural utilization of helicopter emergency medical service in patients with ST-elevation myocardial infarction in Poland. Kardiol. Pol. 2020, 78, 284–291. [Google Scholar] [CrossRef]
- El Haj, C.; Lichtenberg, M.; Nielsen, K.L.; Bjarnsholt, T.; Jensen, P.Ø. Catalase protects biofilm of Staphylococcus aureus against daptomycin activity. Antibiotics 2021, 10, 511. [Google Scholar] [CrossRef]
- Wolfensberger, A.; Sax, H.; Weber, R.; Zbinden, R.; Kuster, S.P.; Hombach, M. Change of antibiotic susceptibility testing guidelines from CLSI to EUCAST: Influence on cumulative hospital antibiograms. PLoS ONE 2013, 8, e79130. [Google Scholar] [CrossRef]
- Gurung, R.R.; Maharjan, P.; Chhetri, G.G. Antibiotic resistance pattern of Staphylococcus aureus with reference to MRSA isolates from pediatric patients. Future Sci. OA 2020, 6, FSO464. [Google Scholar] [CrossRef]
- Locatelli, C.; Gattolin, S.; Monistero, V.; Castiglioni, B.; Moroni, P.; Addis, M.F.; Cremonesi, P. Staphylococcus aureus coa gene sequence analysis can prevent misidentification of coagulase-negative strains and contribute to their control in dairy cow herds. Front. Microbiol. 2023, 14, 112030. [Google Scholar] [CrossRef] [PubMed]
- Akineden, O.; Hassan, A.A.; Schneider, E.; Usleber, E. A coagulase-negative variant of Staphylococcus aureus from bovine mastitis milk. J. Dairy Res. 2011, 78, 38–42. [Google Scholar] [CrossRef] [PubMed]
- Tavenesch, F.; Lina, G.; Henry, T. Staphylococcus aureus hemolysins, bi-component leukocidins, and cytolytic peptides: A redundant arsenal of membrane-damaging virulence factors? Front. Cell. Infect. Microbiol. 2012, 2, 12. [Google Scholar] [CrossRef]
- Du, Y.; Liu, L.; Zhang, C.; Zhang, Y. Two residues in Staphylococcus aureus α-hemolysin related to hemolysis and self-assembly. Infect. Drug Resist. 2018, 11, 1271–1274. [Google Scholar] [CrossRef] [PubMed]
- Wang, L.J.; Yang, X.; Qian, S.Y.; Liu, Y.C.; Yao, K.H.; Dong, F.; Song, W.Q. Identification of hemolytic activity and hemolytic genes of Methicillin-resistant Staphylococcus aureus isolated from Chinese children. Chin. Med. J. 2020, 133, 88–90. [Google Scholar] [CrossRef]
- Roline, C.E.; Crumpecker, C.; Dunn, T.M. Can methicillin-resistant Staphylococcus aureus be found in an ambulance fleet? Prehospital Emerg. Care 2007, 11, 241–244. [Google Scholar] [CrossRef]
- El-Mokhtar, M.A.; Hetta, H.F. Ambulance vehicles as a source of multidrug-resistant infections: A multicenter study in Assiut City, Egypt. Infect. Drug Resist. 2018, 11, 587–594. [Google Scholar] [CrossRef] [PubMed]
- Calà, C.; Amodio, E.; Di Carlo, E.; Virruso, R.; Fasciana, T.; Giammanco, A. Biofilm production in Staphylococcus epidermidis strains, isolated from the skin of hospitalized patients: Genetic and phenotypic characteristics. New Microbiol. 2015, 38, 521–529. [Google Scholar]
- Taylor, T.A.; Unakal, C.G. Staphylococcus aureus Infection; StatPearls: Treasure Island, FL, USA, 2024. [Google Scholar]
- Nowakowicz-Dębek, B.; Pawlak, H.; Wlazło, Ł.; Maksym, P.; Kapica, J.; Chmielowiec-Korzeniowska, A.; Trawińska, B. Evaluating bioaerosol exposure among bus drivers in the public transport sector. J. Occup. Environ. Hyg. 2017, 14, D169–D172. [Google Scholar] [CrossRef]
- Tavares, A.; Nielsen, J.B.; Boye, K.; Rohde, S.; Paulo, A.C.; Westh, H.; Schønning, K.; de Lencastre, H.; Miragaia, M. Insights into alpha-hemolysin (Hla) evolution and expression among Staphylococcus aureus clones with hospital and community origin. PLoS ONE 2014, 9, e98634. [Google Scholar] [CrossRef][Green Version]
- Mackenzie, M.; Pilbery, R. The impact of an ambulance vehicle preparation service on the presence of bacteria: A service evaluation. Br. Paramed. J. 2019, 3, 27–31. [Google Scholar] [CrossRef] [PubMed]
- Kalu, I.C.; Kao, C.M.; Fritz, S.A. Management and Prevention of Staphylococcus aureus Infections in Children. Infect. Dis. Clin. N. Am. 2022, 36, 73–100. [Google Scholar] [CrossRef] [PubMed]

| No. | Collection Site | Chapman | Coagulase | Catalase | Gram | Haemolysis | FOX |
|---|---|---|---|---|---|---|---|
| 1. | Stasis (plastic part) | + | − | + | Z+ | Β | S |
| 2. | Stasis (material part) | + | + | + | Z+ | Β | R |
| 3. | SpO2 sensor | + | + | + | Z+ | Β | R |
| 4. | Pulse oximeter case | + | + | + | Z+ | Β | R |
| 5. | Pressure cuff | + | + | + | Z+ | Β | S |
| 6. | Stethoscope head | + | + | + | Z+ | Β | R |
| 7. | Stethoscope cable | + | − | + | Z+ | Β | R |
| 8. | Steering wheel—spot 1 | + | + | + | Z+ | Β | S |
| 9. | Steering wheel—spot 2 | + | + | + | Z+ | Β | S |
| 10. | Steering wheel—spot 3 | + | + | + | Z+ | Β | S |
| 11. | ECG cables | + | + | + | Z+ | Β | S |
| 12. | Glucometer | + | + | + | Z+ | Β | R |
| 13. | Defibrillator right panel | + | + | + | Z+ | Β | R |
| 14. | Defibrillator left panel | + | − | + | Z+ | Β | S |
| 15. | Defibrillator screen | + | + | + | Z+ | Β | S |
| 16. | Stretcher (head support)—spot 1 | + | + | + | Z+ | Β | S |
| 17. | Stretcher (torso)—spot 2 | + | + | + | Z+ | Β | S |
| 18. | Stretcher (torso)—spot 3 | + | + | + | Z+ | Β | S |
| 19. | Stretcher (legs)—spot 4 | + | + | + | Z+ | A | S |
| 20. | Door handle (med. compartment) | + | + | + | Z+ | Β | R |
| Antibiotics Used [μg] | MRSA (n = 8) | MSSA (n = 12) | Sensitivity of Strains Isolated [%] | Resistance of Strains Isolated [%] | ||
|---|---|---|---|---|---|---|
| Resistant | Sensitive | Resistant | Sensitive | |||
| Penicillin (PG 1) | 7 (87.5%) | 1 (12.5%) | 7 (58.33%) | 5 (41.66%) | 30 | 70 |
| Ticarcillin (TC 75) | 7 (87.5%) | 1 (12.5%) | 4 (33.33%) | 8 (66.66%) | 45 | 55 |
| Cefoxitin (FOX 30) | 8 (100%) | 0 | 0 | 12 (100%) | 60 | 40 |
| Cefotaxime (CTX 5) | 8 (100%) | 0 | 12 (100%) | 0 | 0 | 100 |
| Streptomycin (S 10) | 1 (12.5%) | 7 (87.5%) | 0 | 12 (100%) | 95 | 5 |
| Ciprofloxacin (CIP 5) | 3 (37.5%) | 5 (62.5%) | 0 | 12 (100%) | 85 | 15 |
| Clindamycin (CD 2) | 6 (75%) | 2 (25%) | 3 (25%) | 9 (75%) | 55 | 45 |
| Erythromycin (E 15) | 7 (87.5%) | 1 (12.5%) | 4 (33.33%) | 8 (66.66%) | 45 | 55 |
Disclaimer/Publisher’s Note: The statements, opinions and data contained in all publications are solely those of the individual author(s) and contributor(s) and not of MDPI and/or the editor(s). MDPI and/or the editor(s) disclaim responsibility for any injury to people or property resulting from any ideas, methods, instructions or products referred to in the content. |
© 2024 by the authors. Licensee MDPI, Basel, Switzerland. This article is an open access article distributed under the terms and conditions of the Creative Commons Attribution (CC BY) license (https://creativecommons.org/licenses/by/4.0/).
Share and Cite
Leszczyński, P.K.; Olędzka, A.; Wierzchowska, K.; Frankowska-Maciejewska, A.; Mitura, K.M.; Celinski, D. Occurrence and Phenotypic Characteristics of Methicillin-Resistant Staphylococcus aureus (MRSA) in Emergency Medical Service Ambulances as a Potential Threat to Medical Staff and Patients. J. Clin. Med. 2024, 13, 7160. https://doi.org/10.3390/jcm13237160
Leszczyński PK, Olędzka A, Wierzchowska K, Frankowska-Maciejewska A, Mitura KM, Celinski D. Occurrence and Phenotypic Characteristics of Methicillin-Resistant Staphylococcus aureus (MRSA) in Emergency Medical Service Ambulances as a Potential Threat to Medical Staff and Patients. Journal of Clinical Medicine. 2024; 13(23):7160. https://doi.org/10.3390/jcm13237160
Chicago/Turabian StyleLeszczyński, Piotr Konrad, Aleksandra Olędzka, Kamila Wierzchowska, Aneta Frankowska-Maciejewska, Krzysztof Marek Mitura, and Daniel Celinski. 2024. "Occurrence and Phenotypic Characteristics of Methicillin-Resistant Staphylococcus aureus (MRSA) in Emergency Medical Service Ambulances as a Potential Threat to Medical Staff and Patients" Journal of Clinical Medicine 13, no. 23: 7160. https://doi.org/10.3390/jcm13237160
APA StyleLeszczyński, P. K., Olędzka, A., Wierzchowska, K., Frankowska-Maciejewska, A., Mitura, K. M., & Celinski, D. (2024). Occurrence and Phenotypic Characteristics of Methicillin-Resistant Staphylococcus aureus (MRSA) in Emergency Medical Service Ambulances as a Potential Threat to Medical Staff and Patients. Journal of Clinical Medicine, 13(23), 7160. https://doi.org/10.3390/jcm13237160

